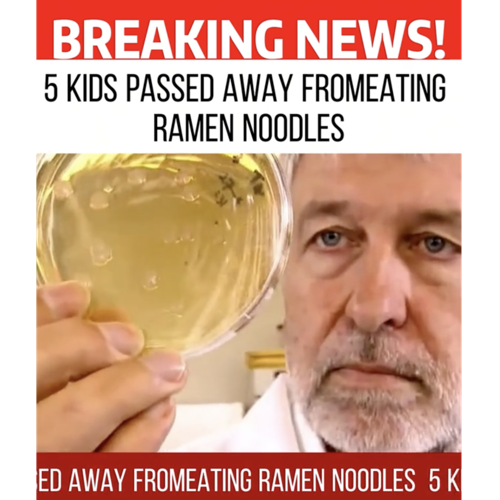

673. Ramen
Dr. Don and Professor Ben talk about the risks from ramen based on a TikTok warning.
Dr. Don - not risky 👍🏼
Professor Ben - not risky 👍🏼
Dr. Don and Professor Ben talk about the risks from ramen based on a TikTok warning.
Dr. Don - not risky 👍🏼
Professor Ben - not risky 👍🏼

Dr. Don and Professor Ben talk about the risks of cracking an egg on your kids head.
Dr. Don - not risky 👍🏼
Professor Ben - not risky 👍🏼

Dr. Don and Professor Ben talk about the risks of decorating the inside of your refrigerator.
Dr. Don - not risky 👍🏼
Professor Ben - not risky 👍🏼

Dr. Don and Professor Ben talk about the risks of the hot new TikTok trend of butter boards.
Dr. Don - not risky 👍🏼
Professor Ben - not risky 👍🏼